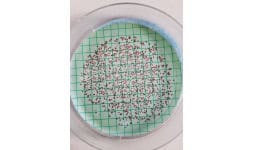

Kit listo para usarse para detectar presencia-ausencia en 24 horas de Coliformes y E. coli en manos y superficies. Incluye medio cromogénico, bolsas estériles hisopos estériles, pipetas desechables

Identificamos si tu semilla sin importar de que tipo de cultivo sea esta contaminada con virus, bacterias u hongos que puedan afectar desde la germinación, crecimiento o producción

Paquete de fisicoquímicos para semillas

Muestreo y Análisis de agua NORMA Oficial Mexicana NOM-127-SSA1-2021, Agua para uso y consumo humano. Límites permisibles de la calidad del agua.

Muestreo y análisis NORMA Oficial Mexicana NOM-002-semarnat-1996

Amigo productor, te apoyamos con el análisis de las características fisicoquímicas del agua y suelo. Así como de las soluciones nutritivas que emplees en tu cultivo

Método acreditado para la determinación de organismos coliformes totales, fecales y E. coli genérica; así como Salmonella spp. En cuanto a la parte fisicoquímica se toma como base los requerimientos

Análisis microbiológico y fisicoquímico de agua Método acreditado para detección de organismos coliformes y salmonella en agua. AOAC Official Method 999.09 Detection of Motile and No-Motile Salmonella

Diagnóstico de pleuroneumonía contagiosa porcina, Pasteurella multocida en cerdos; bronquitis infecciosa y lanringotraqueitis infecciosa aviar por PCR


Análisis rápido de Listeria monocytogenes por PCR bajo aprobación AOAC-PTM y/o USDA-FSIS para muestras de vegetales, superficies y otros más

Determinación de bacterias ácido lácticas, mesofilos, psicotrófas en carne. Estos parámetros te permitirán establecer la vida de anaquel de tu producto. De la misma forma dependiendo el tipo de carne,

Determinación de vitaminas B1, B2, B3, B5, B6 y B9 en alimentos por HPLC-DAD Método interno por HPLC - DAD basado en 1) Eitenmiller, R., Landen Jr., W., Ye, L. (2007). Vitamin analysis for the health

Análisis multiresidual de plaguicidas en aguacate. MÉTODO ACREDITADO Método Interno INOQ-GC-01. AOAC Official Method 2007.01 Pesticide Residues in Foods. Método Interno INOQ-LC-01. AOAC Official

Cuenta de mohos y levaduras en alimentos (UFC/g) 5 días de incubación a 25±1°C. Alimentos frescos (frutos, vegetales hortalizas), congelados y preparados. NOM-111-SSA1-1994 Bienes y servicios. Método

Determinamos mediante un análisis bromatológico la calidad nutrimental de tu forraje que apoye la formulación de tu dieta de ganado. También podemos apoyarte en el estudio de MS requerido si te

Determinación de Coliformes totales, coliformes fecales y Escherichia coli (NMP/g) (NMP/mL) alimentos, agua, hielo y bebidas de consumo humano. MÉTODO ACREDITADO bajo el Bacteriological Analytical
Emitimos un informe de resultados en la detección de organismos coliformes totales acreditado por la ema, método basado en el BAM y por el ensayo rápido de PETRIFILM. AOAC Official Methods 991.14

Determinación de cuenta de bacterias mesofílicas aerobias por método de vaciado en placa para agua y alimentos. MÉTODO ACREDITADO bajo la NOM-092-SSA1-1994, Bienes y servicios. Método para la cuenta
